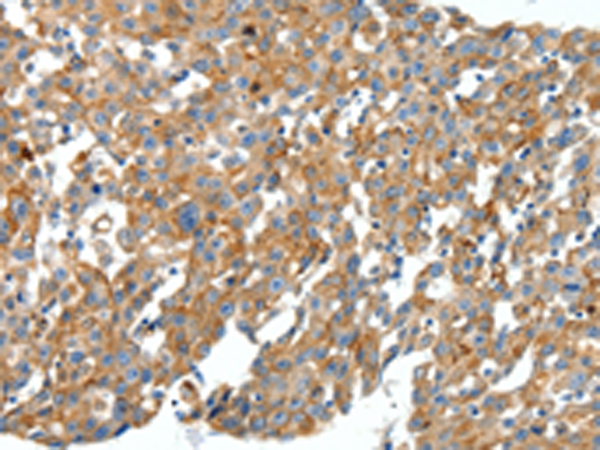

|
Background: |
This gene encodes a stromal cell-derived alpha chemokine member of the intercrine family. This gene product and its receptor CXCR4 can activate lymphocytes and have been implicated in the metastasis of some cancers such as breast cancer. Mutations in this gene are associated with resistance to human immunodeficiency virus type 1 infections. Multiple transcript variants encoding different isoforms have been found for this gene. |
|
Applications: |
ELISA, IHC |
|
Name of antibody: |
CXCL12 |
|
Immunogen: |
Synthetic peptide of human CXCL12 |
|
Full name: |
chemokine (C-X-C motif) ligand 12 |
|
Synonyms: |
IRH; PBSF; SDF1; TLSF; SDF1A; SDF1B; TPAR1; SCYB12 |
|
SwissProt: |
P48061 |
|
ELISA Recommended dilution: |
2000-5000 |
|
IHC positive control: |
Human breast cancer and Human cervical cancer |
|
IHC Recommend dilution: |
50-200 |
購物車
購物車 幫助
幫助
 021-54845833/15800441009
021-54845833/15800441009
